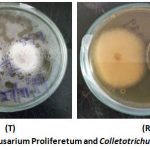
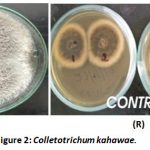
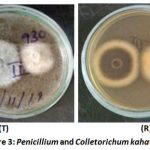
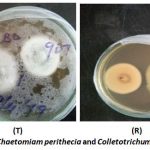
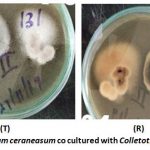
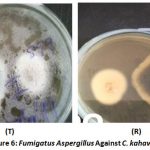

Introduction
Coffee is one of the highly traded commodities in the world, with the current world production estimated to be 170 million bags1. Coffee is a major cash crop in Kenya and is ranked fifth contributor to GDP after horticulture, tourism, tea, and diaspora remittances1. Coffee production is constrained by high cost of production, use of inappropriate technology, prohibitive process of access to credit by the farmers and two major diseases namely Coffee Berry Disease (CBD) and Coffee Leaf Rust (CLR).
The disease-causing organisms cannot be eliminated from the environment. Management measures such as chemical methods, cultural methods and biological control are used to control the diseases2. Environmental pollution due to inappropriate, excessive and/or misuse of agrochemicals, strict regulations on chemical pesticide use, has led to considerable changes in people’s attitudes towards the use of pesticides3.
The use of eco-friendly management of diseases and pests such as biocontrol has been researched on as a complementary approach to ecological harmful approach4. Current sustainability involves exploitation of microbial activities affecting plant growth and development4. Most biological control agents are classified into three categories: Natural, classic and augmentative. Natural biocontrol agent describes the effects of the indigenous natural enemies present in nature5. Classical biological control (BC), also referred to as introduction biocontrol6, is introduction of one or more biocontrol agents, mostly from a pest’s origin area, to control the pest in an area where it is being introduced. Augmentative biocontrol on the other hand using involves the production and release of BC agents into specific crop situations, in which they cause mortality of the target pest, but are not expected to persist from one cropping cycle to the next4. Savings in yields due to natural BC are already recognised to be greater than those from augmentative BC or classical BC 7.
There are usually diverse sets of micro-organisms which associated with plant pathogens, and they negatively interact with the pathogens. The interactions include parasitism, competition, and direct antagonism8. Competition refers to interaction amongst species that require some limited environmental growth factors. An example of competition is the suppression of Pythium ultimum by Enterobacter cloacae9. Parasitism is an interaction between organisms or populations whereby one is harmed and the other benefits. A classic model of parasitism is expressed in hypovirulenc of Cryphonectria parasitica by a virus10. Direct antagonism refers to the interaction of organisms in which, activities of one organism exert inhibitory effect on progression or survival of the other in the same environment. An example of direct antagonism is exhibited by Seratia marcescens in controlling Scerotium rolfsii mediated by expression of chitanase.11. The study was carried out to assess antagonism of various fungal pathogens as potential bio control agent in managing Colletotrichum kahawae in vitro.
Materials and Methods
Study Site
The study was conducted in Kirinyaga County located in central Kenya. The County is located on the South-Eastern slopes of Mt Kenya in Central part of Kenya. It lies between latitude 0.6591S and longitude 37.3827E. The mean temperature of the coffee growing zone is 20°C13. One hundred (100) farms were selected from each of the four sub counties (Kirinyaga East, West, Central and Mwea East). In addition, the farms were selected based on 3 different zones i.e. upper midland 1,2 and 3 the agro ecological zones as indicated in Table 1. The farms were randomly selected at an interval of 1 km apart.
Table 1: Climatic Conditions in the Coffee Agro-Ecological Zones in Kirinyaga County.
| Zones | Height above sea level (ASL) | Average Temperature (oC) |
Mean annual rainfall (mm) |
| Coffee tea zone | 1520-1820 | 18.4 | 1550 |
| Main Coffee zone | 1400-1580 | 19.5 | 1360 |
| Marginal coffee zone | 1310-1400 | 20.3 | 1175 |
Source: Farm management handbook of Kenya 14.
Soil Sampling
Plant residues were removed from the soil surface, and a soil auger was used to scoop soil from the plough layer (0-15 cm in depth). Soil sample from seven different points was collected following a Z-shape from each farm following the method described by Gaddeyya 15. The sample was then thoroughly mixed in a labelled sample bag and transported to the laboratory for isolation of microbes.
A Sampling of Coffee Berries
Berries at expanding stage were handpicked from coffee plants following a Z-shape pattern around the farm. Ten 10 berries were collected from five points along with the Z pattern in each tree with CBD infection, the berries were then put in a plastic bag with labels indicating the name of the farmer, farm number and date of sampling. These were taken to the laboratory in different batches for isolation of the surface microbes.
Media Preparation
About 15.6g of commercially prepared dehydrated potato dextrose agar (PDA) was weighed into a flat bottomed flask. Four hundred (400) mls of the distilled water was added in conical flask and swirled to dissolve. The solution was then autoclaved at a temperature of 121°C for fifteen minutes. The solution was then allowed to cool at 27°C. It was then dispensed to half fill 9 cm- Petri dishes. This was done in aseptic condition to avoid contamination.
Isolation of Fungi from Soil
Fungi were isolated by soil dilution method16. To obtain a stock solution, 1g of the soil was added to 9 ml of distilled water in a sterilized McCartney tubes and gently shaken for better distribution of soil particles. Serial dilutions were prepared from the stock suspension to obtain 10-1, 10-2 and 10-3 but only 10-2 and 10-3 were plated on the culture media. Starting with the weakest dilution (10-3), 1 ml of the medium suspension was drawn into a pipette and dispensed onto each of the 3 Petri dishes (Labelled 10-3) with the solidified PDA media. This was spread over the entire surface using a L- stirring rod. The procedure was repeated for 10-2 dilutions. The whole procedure was then repeated for all the soil samples in three replicates for each sample. The Petri dishes were then sealed with Parafilm to prevent contamination. The inoculated Petri dishes were incubated at 27°C for ten days. The colonies were recorded per petri dish for each dilution. The microbes indicative of potential antagonism were then sub-cultured individually in fresh solidified PDA media by scooping the spore from each colony and placing it into a separate petri dish which was incubated for ten days for further identification.
Fungal Isolation from Coffee Berries
Each of the berries were washed using a drop of Teepol® detergent and rinsed twice with double-distilled water. The berries were placed on moist kitchen towel inside plastic lunch boxes to promote sporulation and incubated at room temperature. Berries with the best lesion were selected from the incubated berries for isolation of microbes. Isolation was carried out by excising the whole lesion and suspending it in 10 mls of sterile distilled water in labelled McCartney tube. Serial dilution was made by drawing 1ml from the stock spore suspension medium and dispensed into 9ml distilled water, plated onto PDA in three replicates per dilution then incubated at 27°C for 10 days. Colonies were then sub-cultured and incubated for ten days for further identification as described by Watanabe17.
Identification of the Fungi
The identification of the fungi was based on, microscopic and morphological characteristics such as colour, furrows, aerial mycelium, and pigmentation presence16.
Bio-Control Assay
The inhibitory ability of the test fungi obtained from soil and berries from Kirinyaga was assessed against the test pathogen isolates using the dual culture method. Pairs of the dual culture technique, both the test microorganism and the potential antagonist were cultured on the same plate 3cm apart. This was done by cutting agar discs of 5 mm from 14-day old fungal isolates earlier isolated from soil and berries. These were then inoculated individually on one side of the plate. The same was done for the test pathogen and it was placed 3cm apart distance from the preplaced fungal isolate. Two Agar plugs of the test pathogen were then inoculated in plates just as for the test pathogen and the fungal isolate to serve as the control for the test. The Petri dishes were then incubated at 27°C. The growth diameter of C. kahawae fungi in cultures in presence of antagonist as well as in control was obtained by measuring growth after every 24 hrs until no further growth of the colonies was observed (14 days post-inoculation). The inhibitory potential of the antagonists was determined in terms of decrease in radial growth of C. kahawae in presence of antagonist relative to the control. The percentage growth inhibition was categorized on growth inhibition category scale from 0 to 4 where 0 indicated no growth inhibition; 1, 2,3,4 indicated1-25%, 26-50%, 51-71% and 76-100% respectively.
Data analysis was done using co-stat computer software version 2017. Data values were subjected to analysis of variance for a completely randomized design (CRD). Differences among treatment means were separated using the Least Significant Difference at α = 0.05.
Results and Discussion
Micro-floral tested in vitro for antagonism potential against C. kahawae exhibited different potentials (Table 2). Three out of the five tested isolates significantly inhibited the growth of C. kahawae. The remaining two isolates did not exhibit great potential for inhibition of growth. Antagonist showing growth inhibition values more than 40% were considered potential biocontrol agents. The magnitude effects of the potential antagonist on the growth of C. kahawae are shown in table below:
Table 2: Percentage Growth Inhibition of C. Kahawae by Fungal Isolates.
| Isolate code | Isolate | Growth inhibition (%) |
| A | Fusarium proliferetum | 60 |
| B | Penicilliun | 55 |
| C | Fusarium ceraneasum | 45.45 |
| D | Fumigatus spp | 40 |
| E | Chaetomium perthecia | 18.18 |
| F | Control | 0 |
The growth morphology and colony-front pattern of the isolates observed indicated diffused front with overgrown and pigmented aerial mycelium. The cultured isolates were as shown in figures 2- 7 below. Figure 2 shows C. kahawae plated on the left side of the plate (top side T) and the extreme right of the plate (in the reverse side R). The plates indicate antagonism by Fusarium proliferetum against the test pathogen Colletorichum kahawae.
|
Figure 1: Fusarium Proliferetum and Colletotrichum kahawae. |
There was even growth of Colletotrichum kahawae towards each other and this indicated no inhibition of growth of the fungi (Figure 2).
|
Figure 2: Colletotrichum kahawae. |
Figure 3 shows the Penicillium co-cultured with Colletorichum kahawae with Plate top (T) and reverse (R). The plates indicate antagonism by Penicillium against C. kahawae. The test pathogen Colletorichum kahawae showed uneven radial growth towards the direction of the Penicillium.
|
Figure 3: Penicillium and Colletorichum kahawae. |
Colletotrichum kahawae co cultured with Chaetomiun perithesia is shown in figure 4. The top side of the plate (T) and reverse side (R) show continuous radial growth of the test pathogen Colletotrichum kahawae towards the test isolate Chaetomiam perithecia.
|
Figure 4: Chaetomiam perithecia and Colletotrichum kahawae. |
Figure 5 shows top side of the plate (T) and the reverse side (R) of Fusarium ceraneasum co cultured with Colletotrichum kahawae. The test pathogen as seen in the reverse side of the plate(R) showed irregular growth of Colletorichum kahawae towards the test isolate Fusarium ceraneasum.
|
Figure 5: Fusarium ceraneasum co cultured with Colletotrichum kahawae. |
Irregular growth of Colletorichum kahawae towards Aspergillus fumigatus both in the top side of the plate (T) and the reverse (R) was observed (Figure 6). The reverse side of the plate showed Colletotrichum kahawae’s (right) growth away from the test isolate Fumigatus aspergillus. Topside of the plate (T) showed the test isolate (left) having continuous growth whereas the test pathogen has irregular growth from the test isolate.
|
Figure 6: Fumigatus Aspergillus Against C. kahawae. |
Significant difference (P≤0.05) was indicated on the antagonistic effects of fungal isolates (Table 3). On isolate growth toward the centre of the plate, the difference between was between isolate E and the control. The test pathogen co-cultured against isolates A and B also indicated notable difference cultured alongside E. Growth towards the centre of the plate for test pathogen plated did not indicate difference with isolates C and D (Table 3). The growth of the CBD causative agent away from the centre of the plate co cultured with the test isolates, had significance (P≤0.05) difference for isolates D and E.
Table 3: Antagonistic Effect of the Fungal Isolates.
| Isolate | Isolate growth towards the centre of the plate (cm) | Test pathogen growth towards the centre plate (cm) |
Isolate growth away from the centre of the plate (cm) |
Test pathogen growth away from the centre of the plate. (cm) |
| A
B C D E Control
|
4.80 ab
5.31ab 4.90ab 4.21ab 5.94a 2.93b |
4.59 b
4.99b 5.13a 5.13a 4.23c 5.31a |
5.85 ab
5.44abc 4.97abc 4.29bcd 6.30a 5.21abc |
5.51 ab
5.38ab 5.28ab 5.71a 5.08b 5.21ab |
| LSD (P=0.05) | 1.61 | 0.34 | 1.17 | 0.37 |
| CV (%) | 23.90 | 4.62 | 16.36 | 4.62 |
Figures marked by the same letters down the column are insignificantly different at P≤0.05 (LSD).
In this study, the test pathogen Colletotrichum kahawae was isolated from diseased coffee berries and candidate isolates were isolated from soil and berries from farms which were not sprayed. The use of fungicides against CBD has been shown to induce greater levels of disease under some circumstances17. Farms which fungicides are not applied did not have high levels of CBD and when used intermittently fungicides can make the disease worse 17. The negative effect of fungicides can be attributed to the removal of microorganisms antagonistic to the pathogen and subsequent loss of natural biological control mechanism 17. This effect was studied and indicated that, there was a large difference between microflora on sprayed and unsprayed coffee 19. This study resulted in the primary selection of five potential isolates namely Fusarium proliferetum, Penicillium, Fusarium ceraneasum, Chaetomium perithecia from soil and Fumigatus aspergillus from berries for antagonism of CBD based on inhibition of radial growth of the pathogen. A fraction of the rhizosphere associated fungi isolated from soil and berries for the in vitro screening of antagonism against C. kahawae showed biological activity in terms of antibiosis. This was determined by formation of visibly clear difference C. kahawae and clear zone between the test pathogen and the candidate fungal isolate on the dual culture plate. This indicated that only a proportion of the isolate tested have potential of inhibition. The inhibition rate varied significantly according to the type of antagonist. These findings conquer with previous results by 19 for antagonism of Colletotrichum kahawae by saprophytic coffee surface microflora. This author reported that microorganism showing significant antagonism towards CBD pathogen (filamentous fungi) were present on unsprayed coffee and element of micobiota were shown to have a natural biocontrol effect on the disease. Minimal inhibition of growth of Colletotrichum kahawae on the culture plates indicated no biological activity by the candidate isolate alongside the test fungi.
Findings by Asfaw 4 stepwise testing of specimen from twigs, leafs and berries for biocontrol reported antibiotic filamentous fungi as bio agents as effective bio agents under invitro conditions. This further indicates that, should great concern for biocontrol agents be given for CBD management under in vitro conditions, effective results will be obtained.
Dual culture assay from this study showed that antagonistic isolate Fusarium proliferetum was most efficient in pathogen inhibition whereas Chaetomia perithesia had the least potential. This difference could be due to a number of factors which include competition for nutrients, emission of compounds from the antagonist hindering pathogen development or space competition between the pathogen and the antagonist. Another possible mechanism by which BCAs (Biological control agents) suppress or reduce pathogen infections mycoparasitism interactions is nutrient competition 20, 21. Findings by Masaba further indicated significant antagonism towards the CBD pathogen (filamentous fungi, yeast and Bacteria) present on unsprayed coffee and elements of the microbiota shown as natural biocontrol effect on the disease. All indicate the hope for using antagonistic microorganism for CBD management 9.
Conclusion And Recommendation
Fungal isolates have the potential of controlling CBD. Following indication of potential antagonism of the pathogen by the identified isolates, further research should be done to investigate the other modes of antagonism. In addition, in vivo tests on antagonism should be conducted.
Acknowledgement
The authors extend sincere appreciation to the National Research Fund for funding this research. The coffee farmers and Kirinyaga County Government are thanked for their cooperation and support during the field work. Sincere gratitude to the staff and management of Coffee Research Institute (CRI) for support. This paper is published with the permission of the Director General through Institute Director, CRI in Ruiru, Kenya.
Funding Source
This work was funded by the National Research Fund of Kenya.
Conflict of Interests
The authors have not declared any conflict of interest.
References
- Muriithi, L. W. Impact of coffee certification on smallholder coffee farming in Embu County, Kenya. M.Sc. Thesis. Kenyatta University, Kenya (2016).
- Alwora, G. O., & Gichuru, E. K. Advances in the management of coffee berry disease and coffee leaf rust in Kenya. Journal of Renewable Agriculture, 2 (1): 5-10 (2014).
CrossRef - Özkara, A., Akyıl, D., & Konuk, M. Pesticides, environmental pollution, and health. In Environmental Health Risk-Hazardous Factors to Living Species. IntechOpen. DOI: 10.5772/63094 (2016).
CrossRef - Asfaw, K., Husein, T., Ayalew, A., Dejene, M., & Sahile, S. In vitro Screening and characterizing the most promising antagonistic microorganism as Biocontrol Agent (s) against Colletotrichum kahawae. European Journal of Experimental Biology, 8(1): 1 (2018).
CrossRef - Van Driesche, R. G., & Bellows, T. S. Biology of arthropod parasitoids and predators. In Biological controlSpringer, Boston, MA pp. 309-336 (1996).
CrossRef - Camacho-Cervantes, M., Ortega-Iturriaga, A., & del-Val, E. From effective biocontrol agent to successful invader: the harlequin ladybird (Harmonia axyridis) as an example of good ideas that could go wrong. Peer J, 5: e3296 (2017).
CrossRef - Fiedler, A. K., Landis, D. A., & Wratten, S. D. Maximizing ecosystem services from conservation biological control: the role of habitat management. Biological control, 45(2): 254-271 (2008).
CrossRef - Karki, G., & Aryal, S. Microbial Diversity and Ecosystem Functioning. Journal of Microbiology and experimentation, 6 (1) DOI: 10.15406/jmen.2018.06.00184 (2018).
- Van Dijk, K., and Nelson, E. B. Fatty acid competition as a mechanism by which Enterobacter cloacaesuppresses Pythium ultimum sporangium germination and damping-off. Appl. Environ. Microbiol. 66:5340-5347 (2000)
CrossRef - Milgroom, M. G., & Cortesi, P. Biological control of chestnut blight with hypovirulence: a critical analysis. Rev. Phytopathol., 42, 311-338 (2004).
CrossRef - Ordentlich, A., Elad, Y., Chet, I. The role of chitinase of Serratia marcescensin the biocontrol of Sclerotium rolfsii. Phytopathology, 78:84-88 (1988)
CrossRef - Masaba DM, Waller JM, Coffee Berry Disease: the current status. In: BaileyJA, JegerMJ,eds. Colletotrichum; Biology, Pathology and Control. Wallingford, UK: CABI, 237–249 (1992).
- Ogolla, O. F., & Neema, D. Cultural, Morphological and Biochemical Identification of Xanthomonas Spp the Causative Agent of Bacteria Leaf Spot in Tomatoes in Wanguru, Mwea, Kirinyaga County, Kenya. International Journal of Research and Innovation in Applied Science, IV, 44-48 (2019).
- Jaetzold, R., Schmidt, H., Hrnetz, B., & Shisanya, C. Farm management handbook Vol II, Part C, East Kenya. Subpart C1, Eastern Province. Ministry of Agriculture, Nairobi Kenya (2006).
- Gaddeyya, G., Niharika, P. S., Bharathi, P., & Kumar, P. R. Isolation and identification of soil mycoflora in different crop fields at Salur Mandal. Advances in Applied Science Research, 3(4): 2020-2026 (2012).
- Reddy, B. N., Saritha, K. V., & Hindumathi, A. In vitro screening for antagonistic potential of seven species of Trichoderma againts different plant pathogenic fungi. Journal of Biology, 2:29-36 (2014).
- Hagiwara, D., Watanabe, A., Kamei, K., & Goldman, G. H. Epidemiological and genomic landscape of azole resistance mechanisms in Aspergillus fungi. Frontiers in microbiology, 7, 1382 (2016).
CrossRef - Gichuru, E. Laboratory screening of some saprophytic coffee surface microflora antagonistic to Colletotrichum kahawae.Agronomie africaine, 17(2):73-80 (2005).
CrossRef - Masaba, D. M. The role of saprophytic microflora in the development of Coffee Berry Disease (Colletotrichum coffeanum) in Kenya. D. Thesis, University of Reading (1991).
- Kim, S. H., & Vujanovic, V. Relationship between mycoparasites lifestyles and biocontrol behaviors against Fusarium spp. and mycotoxins production. Applied Microbiology and Biotechnology, 100(12): 5257-5272 (2016).
CrossRef - Whipps, J. M. Microbial interactions and biocontrol in the rhizosphere. Journal of experimental Botany, 52(suppl_1), 487-511 (2001).
CrossRef


